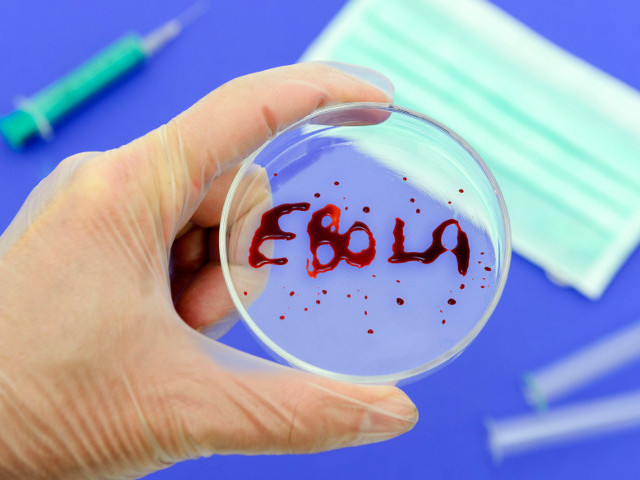

От Эбола умерли уже 1013 человек. Белый дом отправляет в Либерию экспериментальную вакцину
Американский Белый дом удовлетворил запрос властей Либерии на предоставление образцов экспериментальной вакцины для борьбы с болезнью, вызванной вирусом Эбола.
Как уточняется на официальном сайте главы Либерии Эллен Джонсон-Серлиф, лекарство будет направлено на лечение либерийских врачей, инфицированных вирусом, передает ИТАР-ТАСС.
Свое разрешение на транспортировку вакцины дало американское Управление по санитарному надзору за качеством пищевых продуктов и медикаментов. "Экспериментальные препараты будут доставлены в страну представителем американских властей позже на этой неделе", - говорится в сообщении.
Кроме того, к концу недели ожидается прибытие в Либерию экспериментальной сыворотки для борьбы с вирусом от Всемирной организации здравоохранения (ВОЗ). Она также будет направлена на лечение пострадавших медиков.
По последним данным ВОЗ, число жертв вспышки смертельно опасного заболевания в странах Западной Африки увеличилось до 1013 человек. Всего заразились 1848 человек.
Лишь с 7 по 9 августа, информирует специальное агентство ООН в области здравоохранения, в Гвинее, Либерии, Сьерра-Леоне отмечено 69 новых случаев опасного заболевания, 52 из которых имели летальных исход.
В статистику включены не только лабораторно подтвержденные случаи смерти от болезни (660 и 1176 соответственно), но также случаи с подозрением на нее.
Большинство людей от болезни, вызванной вирусом Эбола, умерли в Гвинее, где вспышка началась в декабре прошлого года, - 373 человека. В соседней Либерии скончались 323 человека, в Сьерра-Леоне - 315. Число летальных исходов в самой густонаселенной стране Африки, Нигерии, не изменилось - здесь от Эболы скончались два человека.
В минувшую пятницу, 8 августа, глава ВОЗ Маргарет Чэнь назвала вспышку вируса Эбола самой крупной за 40 лет и объявила ее угрозой международного значения.
Накануне в Женеве ВОЗ провела в режиме телеконференции совещание экспертов по медицинской этике, которые должны были дать ответ на вопрос - возможно ли для борьбы с заболеванием, от которого нет зарегистрированных вакцин или лекарств, использовать препараты, которые показали свою эффективность, но никогда не тестировались на людях. Итоги заседания должны быть подведены сегодня.